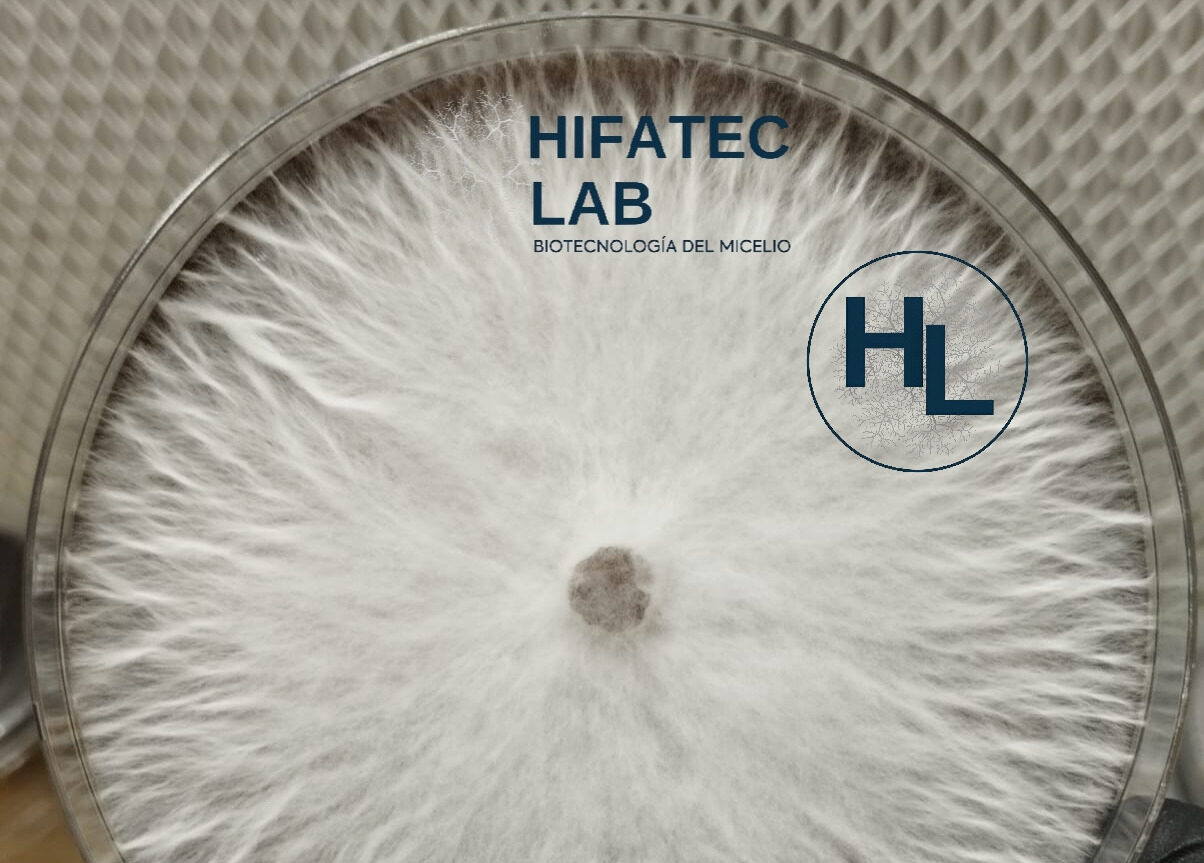

¡Domina el cultivo de hongos desde casa con nuestra guía profesional!
En Hifatec Lab, queremos que tu experiencia sea sencilla, limpia y, sobre todo, efectiva. Por eso, hemos liberado nuestra Guía […]
¡Domina el cultivo de hongos desde casa con nuestra guía profesional! Leer más »